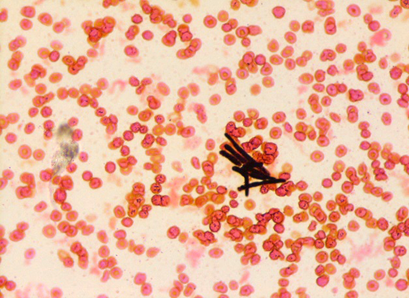

A 23 year old female with a previous medical history of endocarditis, hepatitis C, IV drug use, and aortic insufficiency status post emergent aortic valve replacement, presented to the ER in septic shock. After one week of hospitalization, she left against medical advice, and did not complete her prescribed course of antimicrobials.
One month later, she returned to the ER with tachypnea, lactic acidosis, and altered mental status, secondary to septic shock and she was admitted to the ICU. She was started on broad spectrum antibiotics based on the cultures from her previous hospitalization. Within one day, blood cultures from her central line were positive for growth of Serratia marcescens. Echocardiogram demonstrated prosthetic valve endocarditis with severe aortic regurgitation. Previous imaging had shown scattered septic emboli throughout her viscera, extremities, and now, MRI/MRA revealed cerebral lesions as well.
Ten and twelve days into her current hospitalization, blood and heart valve tissue cultures (respectively) were both positive for growth of the below-pictured organism. What is this causative organism?

MALDI-ToF-MS identified the yeast from the blood culture and heart valve as Trichosporon asahii. It is a yeast-like basidiomycete. It is commonly found in soil, but is also a normal colonizer of mucous membranes of the GI and respiratory epithelium, and skin. It may also infect hair shafts and is the causative agent in “white piedra”. It is involved in several opportunistic infections in the immunosuppressed. Of all Trichosporon species, T. asahii is the most common cause of disseminated infection, especially in those with hematologic malignancies (leukemia, multiple myeloma, aplastic anemia, lymphoma), solid tumors, AIDS, and solid tumors. In immunocompetent patients, Trichosporon may cause infections including endophthalmitis following cataract surgery, endocarditis, following prosthetic heart valve replacement (as seen in this patient), and peritonitis in IV drug abusers or those receiving continuous ambulatory peritoneal dialysis (CAPD).
Trichosporon colonies are powdery, cream-colored, and with age, may develop surface wrinkles. On cornmeal Tween 80, yeast can either grow alone or in short chains. True and pseudohyphae may be seen. Barrel-shaped arthroconidia are typically present. Variable growth is seen on media containing cycloheximide. It may also cause Cryptococcal antigen agglutination tests to be falsely positive.
Diagnosis is typically via blood culture.
Combination therapy with amphotericin B and an -azole drugs seems to be the most successful treatment option.
Resources
- Brandt, ME, Lockhart, SR. Recent developments with Candida and other opportunistic yeasts. Curr Fungal Infect Rep. 6(3); 170-177. 2012.
- Dimorphic Systemic Mycoses | Mycology | University of Adelaide Accessed 10/22/21.
- Love, G. Mycology Benchtop Reference Guide. College of American Pathologists. P20. 2013.
- Maves, RC. Trichosporon Infections. Emedicine.medscape.com. Updated Feb 12, 2018. Accessed 10/18/21.
- Procop, GW, Church, DL, Hall, GS et al. Koneman’s Color Atlas and Textbook of Diagnostic Microbiology. 7th Edition. P 1366-1369. Wolter’s Kluwer Health. 2017.
- Ramos, JM, Cuenca-Estrella, M, Gutierrez, F, et al. Clinical case of endocarditis due to Trichosporon inkin and antifungal susceptibility profile of the organism. J Clin Microbiology. 42(5):2341-4. 2004.
- Trichosporon | Mycology | University of Adelaide Accessed 10/22/21.
-Jenny Pfeiffer, MD is a 1st year Anatomic and Clinical Pathology resident at the University of Vermont Medical Center.

-Christi Wojewoda, MD, is the Director of Clinical Microbiology at the University of Vermont Medical Center and an Associate Professor at the University of Vermont.
Great case